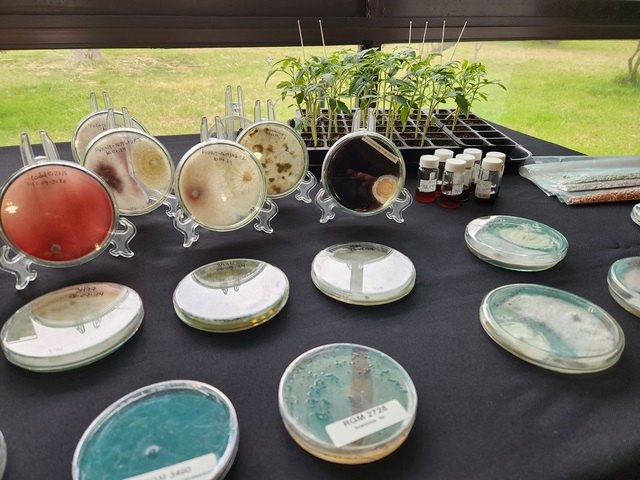
ChillanOnline's tweet image. Durante dos días Chillán será la capital mundial del Control Biológico y de los Bioinsumos chillanonline.cl/V7/2024/09/27/… a través de @CHILLANONLINE

You might like
Durante 2 días Chillán será capital mundial del Control Biológico y de Bioinsumos.Principales científicos y especialistas del orbe se reunirán en INIA Quilamapu entre el 16 y 17 de octubre, en la 2a Feria Tecnológica de Control Biológico y la 1ª Feria Tecnológica de Bioinsumos.




Durante dos días Chillán será la capital mundial del Control Biológico y de los Bioinsumos chillanonline.cl/V7/2024/09/27/… a través de @CHILLANONLINE

✅️Sé parte de la Feria Tecnológica de Control Biológico y la primera Feria Tecnológica de Bioinsumos 🤩🔬. Lorena Barra del Centro Nacional de Bioinsumos INIA, expondrá en la charla titulada “Avances tecnológicos y oportunidades de innovación en el sector de los bioinsumos”.

A minutos de empezar el webinar sobre "Avances en el manejo orgánico de Drosophila suzukii".

Browse our #handbook collection on #Diptera 🪰 Use code HANDBOOK20 for a #discount on all RES #Handbooks - Members can log in for 30% off, plus the code at checkout for even bigger savings. ⏰ Sale ends 30 November #BuyNow: royensoc.co.uk/publications/h…
Bajo el #MarDePlástico de #Almería hay un "bosque" de 30000 ha fijando #CO2




INIA Quilamapu, encabezado por su DR Marcelino Claret, participó en el Taller "Desafíos Regionales en Materia Fitosanitaria", para Jefes de División de Fomento Productivo, municipios y SAG, de O'Higgins a Los Ríos. @LDevotto expuso sobre los desafíos en #drosophilasuzukii




La charla magistral de la Dra. Sampedro resume un enfoque basado en cambiar el comportamiento de las bacterias fitopatógenas, en lugar de solo inundar los cultivos con pesticidas para matarlas. #Vsimposiochilenocontrolbiologico

Si aún no te has inscrito puedes hacerlo incluso hasta el jueves 1 de septiembre. Gratis y online. Expositores de 11 países y asistentes desde 29 países
Buenos días a los casi 1.500 personas que se inscribieron en nuestro #Vsimposiochilenocontrolbiologico y a los más de 150 investigadores/as, estudiantes y profesionales que enviaron sus trabajos. Gracias por hacer posible el evento!!

Increíble y emocionante
IMPRESIONANTE | 🥹 El momento en que un Royal Marine británico retirado y que padece de la enfermedad de Parkinson ve cómo su vida cambia en unos segundos, gracias a la técnica avanzada de Estimulación Cerebral Profunda (DBS). Maravillas de la ciencia y el ingenio humano.
Great first @SocInvPathol #SIP22 presentation from Mark Davis regarding the use of chemical pesticides and biopesticides! "The future is bright for biocontrol" - Microbial Control Division Symposium Well done and extremely interesting!

'Shaping the Future for Pollinators, Innovations in Farmed Landscapes'.. an event with @bes_aeg @RoyEntSoc online and hosted in Slough 🇬🇧 65+ presenters across 9 oral and poster sessions 📅 Sept 6-8 In-person reg by August 16th; online by Sept 1st cvent.me/4x5bKe
The Patagonian cypress (Fitzroya cupressoides) is known for its slow growth and exceptional size. Nicknamed the Gran Abuelo tree (great-grandfather), it stands nearly 200 feet tall, features a trunk 13 feet thick, and has a perimeter of 36 feet.
Chile May Be Home to the World’s Oldest Tree: treehugger.com/chile-home-wor… @ScienceMagazine
Si aún no has enviado tu resumen, ¡Aún tienes tiempo!. No te quedes a fuera, ya tenemos trabajos de varios países de Latinoamérica. El 5 de julio (24:00) se cierra la recepción. Sube tu resumen AQUÍ👇💻 controlbiologicochile.com/Simposio/

Evento gratuito y online
Recuerda que está abierto el plazo hasta el 🚩5 de julio de 2022 para el envío de resúmenes para al🧪🔬🐞🌾 5° Simposio Chileno de Control Biológico. No te lo pierdas, evento on line y gratuito💻 . Sube tu resumen AQUÍ👉🏽controlbiologicochile.com/Simposio/

Recuerda que está abierto el plazo hasta el 🚩5 de julio de 2022 para el envío de resúmenes para al🧪🔬🐞🌾 5° Simposio Chileno de Control Biológico. No te lo pierdas, evento on line y gratuito💻 . Sube tu resumen AQUÍ👉🏽controlbiologicochile.com/Simposio/

Evento gratuito y online
El 31 de agosto, contaremos con la charla magistral del Dr. David Shapiro-Ilan del USDA "Control biológico de plagas usando nematodos entomopatógenos". Te esperamos, inscríbete en👇🏽💻 : us02web.zoom.us/webinar/regist…

Con foco en la AFC, ya que este grupo de agricultoras/es es el más afectado por la plaga @MinagriCL @INDAP_Chile
Destacados asesores privados Óscar Avendaño, Daniel Ortiz y Cristian Torres entregaron su visión sobre problemas y soluciones para el manejo de #drosophilasuzukii, representando a 222 productores de 🍒🍓🫐 y frambuesa de 9 comunas de Ñuble. Coordinó @LDevotto

ARS postdoc Miles Zhang and collaborators revealed the parasitoid wasp Ormyrus labotus, a generalist with 65 known hosts in the literature, to actually be a complex of 16-18 cryptic specialist species each with a much narrower host preference. bit.ly/3L2NCdv #SysEntLab

United States Trends
- 1. Fanone N/A
- 2. Jack Smith N/A
- 3. Arlington N/A
- 4. harry styles N/A
- 5. #Aperture N/A
- 6. Jesse Minter N/A
- 7. Fable N/A
- 8. WE BELONG TOGETHER N/A
- 9. Sinners N/A
- 10. He-Man N/A
- 11. #RavensFlock N/A
- 12. Ivan N/A
- 13. #BTS_ARIRANG N/A
- 14. Maki N/A
- 15. Trinity Rodman N/A
- 16. #YIAYhouse N/A
- 17. Stanford N/A
- 18. Hanoi Jane N/A
- 19. Titanic N/A
- 20. Oscar N/A
Something went wrong.
Something went wrong.















































































































